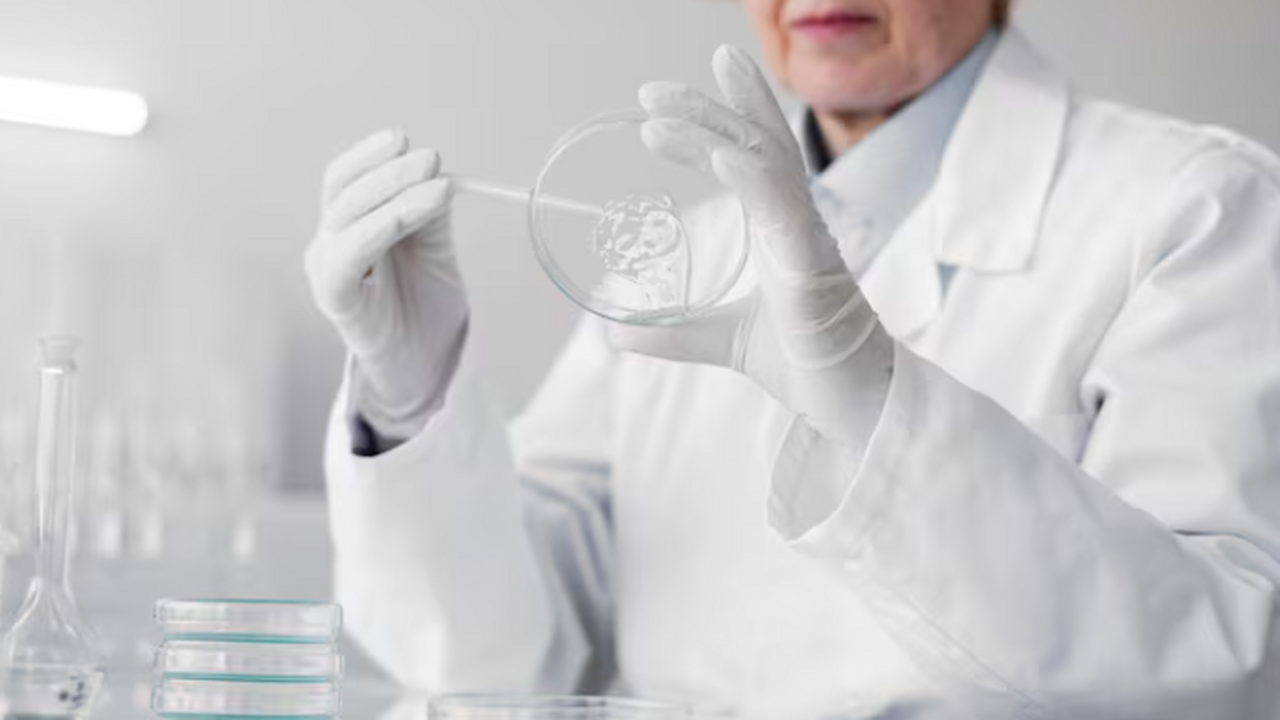
Учёные Томского политехнического университета р...

Ученые нашли дешевый способ получать за минуту светящуюся в темноте керамику
фото: freepik
Учёные Томского политехнического университета разработали новый экономичный метод производства светоизлучающих материалов, занимающий менее одной минуты. Об этом сообщило ТАСС, ссылаясь на официальное заявление пресс-службы ТПУ.
Группа исследователей из ТПУ, в сотрудничестве с коллегами из Томского государственного архитектурно-строительного университета и Томского научного центра Сибирского отделения РАН, адаптировала метод электродугового плазменного синтеза для получения люминесцентной керамики. Данная технология позволяет синтезировать светоизлучающие материалы за значительно сокращённое время без применения дорогостоящего оборудования.
В процессе экспериментов материалы подвергались воздействию электрической дуги в специализированной установке, что приводило к их плавлению за менее чем минуту. После отключения плазменного разряда расплавленный материал затвердевал в течение пяти минут, формируя полусферические изделия. Высокая температура процесса обеспечивала однородность конечного продукта благодаря интенсивным потокам расплава.
Эффективность излучательной способности полученных материалов сопоставима с аналогами, полученными традиционными методами, требующими значительно больше времени и дорогостоящего оборудования. Доцент отделения материаловедения Инженерной школы новых производственных технологий ТПУ Дамир Валиев подчеркнул, что разработанная технология не зависит от изменения химического состава материалов.
По его словам, введение различных активаторов позволяет синтезировать материалы, излучающие свет в различных спектральных диапазонах. Образцы с «красновато-розовым» и «зелёным» свечением могут найти применение в лазерных проекторах для формирования ярких цветных изображений. В будущем учёные планируют разработать высокостабильную инфракрасную керамику для использования в медицинской диагностике сосудистых заболеваний.
Исследователи также установили, что люминесцентные характеристики материалов, такие как интенсивность свечения и время затухания, зависят от их кристаллической структуры. Эти данные представляют значительный интерес для разработки новых оптоэлектронных материалов. Работа получила поддержку гранта Российского научного фонда, а результаты исследования опубликованы в международном журнале Ceramics International.


